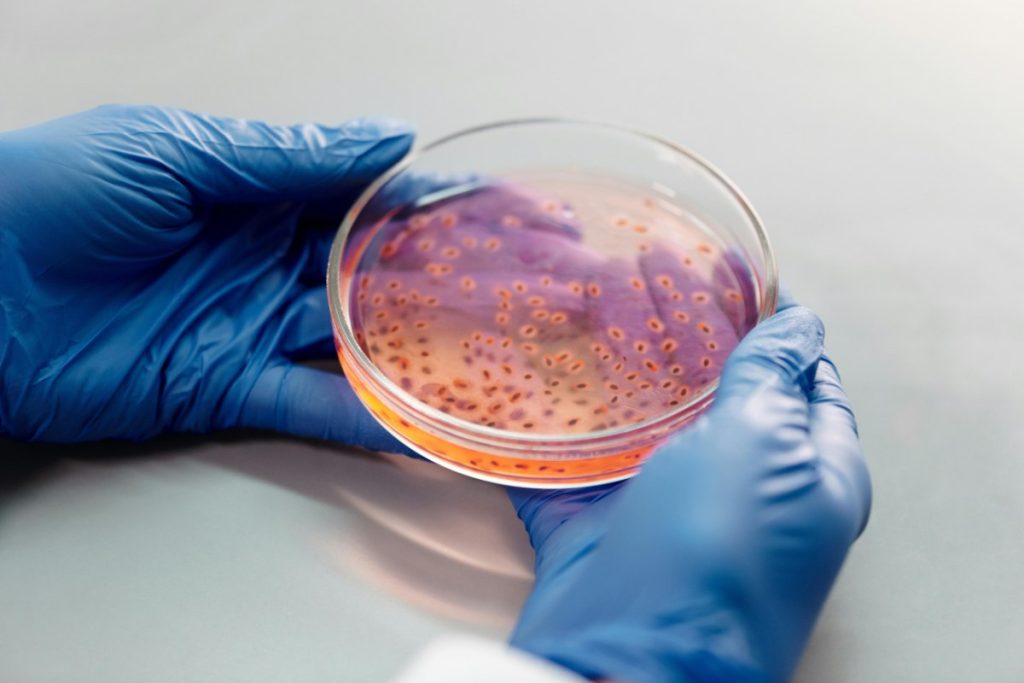
WHO Warns of Deadly Drug-Resistant Microbes

Antibiotics have long been known to disrupt the delicate balance of bacteria living in our intestines. But a new large-scale study from the University of Tartu’s Institute of Genomics in Estonia reveals that they’re far from the only culprits.
According to the research—based on real-world data from over 2,500 samples in the Estonian Biobank—common drugs such as antidepressants, beta-blockers, and anti-anxiety medications can alter the gut microbiome for years, sometimes even decades, after people stop taking them.
The Hidden Legacy of Everyday Medications
The scientists examined stool samples and prescription records of participants to map how various drugs influence gut bacteria. The results were striking: most medications analyzed were linked to measurable, long-term changes in the intestinal microbiome.
The drugs most strongly associated with such effects included:
- Antibiotics, already known to disturb gut flora.
- Antidepressants, particularly selective serotonin reuptake inhibitors (SSRIs).
- Beta-blockers, prescribed for heart conditions such as hypertension and arrhythmias.
- Proton pump inhibitors (PPIs), used to treat reflux and ulcers.
- Benzodiazepines, commonly used to relieve anxiety, insomnia, or muscle spasms.
Even drugs within the same class appeared to have different microbiome effects. For instance, the team found that diazepam and alprazolam, two well-known benzodiazepines, varied significantly in how much they disrupted gut balance.
Decades-Long Impact
Lead author Dr. Oliver Aasmets explained that most microbiome studies focus only on medications patients are currently taking.
“Our results show that even very old drug use can be just as important,” he said. “Past medication history turns out to be an unexpectedly powerful factor in explaining why people’s microbiomes differ.”
This finding, the researchers note, highlights the need to consider a patient’s full pharmaceutical history—not just recent prescriptions—when studying the relationship between gut health and disease.
When Anti-Anxiety Pills Mimic Antibiotics
One of the most surprising discoveries was that benzodiazepines—a class of anti-anxiety drugs—caused microbiome changes similar to those produced by broad-spectrum antibiotics.
To test this further, the researchers ran a follow-up study with a smaller group of volunteers. They observed that starting or stopping certain drugs led to predictable microbiome shifts, suggesting a cause-and-effect relationship.
Even medications taken years ago, such as penicillins, macrolides, or PPIs, left behind detectable microbial signatures.
Real-World Data, Real-World Implications
Co-author Professor Elin Org, a geneticist at the University of Tartu, called the study “the most systematic real-world evaluation” of how long-term drug exposure can shape gut flora.
“We hope these findings encourage both researchers and clinicians to take patients’ medication histories into account when interpreting microbiome data,” she said.
The Bigger Picture
The gut microbiome—trillions of bacteria, fungi, and other microorganisms—plays a critical role in everything from digestion and immunity to mood regulation. Its imbalance, or dysbiosis, has been linked to conditions such as obesity, depression, diabetes, and even neurodegenerative diseases.
This new Estonian research underscores just how deep and long-lasting medication effects on the microbiome can be. What we took years ago may still be quietly shaping our health today.